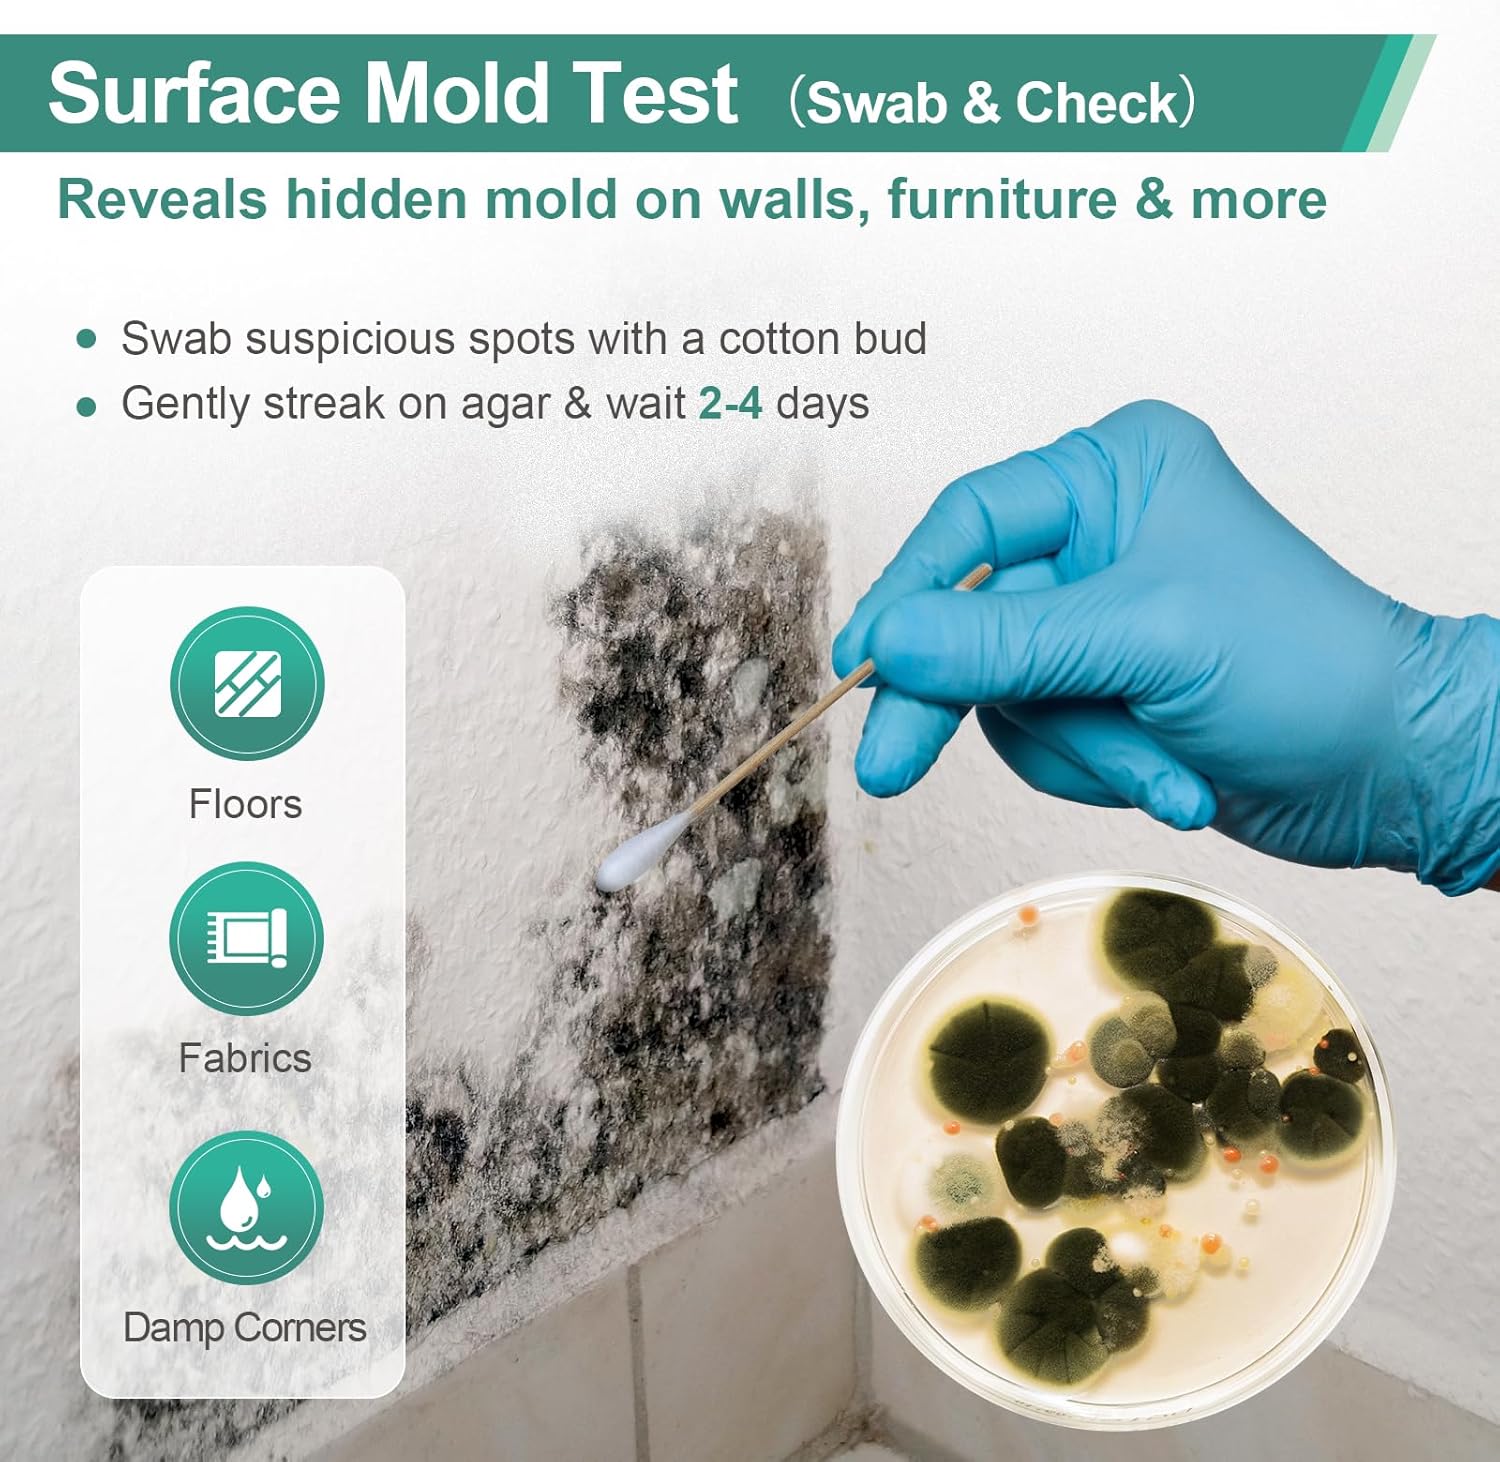
Mold Test Kit for Home Indoor Air Quality Testing Kits Mold Detector(Starting from 10boxes, 120 pieces, MT-120)

Test Kits for health
31 products
Showing 1 - 24 of 31 products
Health & Safety Test Kits – Quick, Reliable, and Easy-to-Use
Protect your home, workplace, and loved ones with our comprehensive range of Health & Safety Test Kits. Designed for fast, accurate, and user-friendly testing, these kits help you detect potential hazards and ensure a safer environment.
Instant Results: Most kits provide results in just seconds, giving you peace of mind without long waiting times.
Wide Applications: Our kits cover a variety of health and safety concerns, including lead detection, water quality testing, and other environmental hazards. Suitable for surfaces, liquids, and everyday items in homes, schools, workplaces, and public spaces.
Simple and Convenient: Easy-to-use instructions allow anyone to perform tests quickly and interpret results accurately. With long shelf life and reliable sensitivity, these kits are a cost-effective way to monitor safety.
Protect What Matters: Stay informed, take preventive measures, and ensure the well-being of your family, employees, and customers with our trusted test kits.